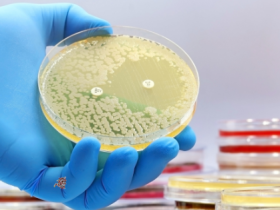

Bakteri adalah salah satu dari mikroorganisme yang memiliki ukuran yang relatif kecil dan merupakan organisme uniselular (sel tunggal). Bakteri juga termasuk kelompok organisme prokariotik, karena materi genetiknya tidak diselubungi oleh membran inti. Bakteri memiliki berbagai macam bentuk, umumnya terbagi menjadi tiga, yaitu bentuk basil (seperti batang), bentuk kokus (seperti bola atau oval), dan bentuk spiral. Ada juga bakteri yang memiliki bentuk bintang dan kotak. Individu-individu bakteri dapat hidup dengan membentuk pasangan, rantai, kluster, dan bentuk lainnya. Bentuk-bentuk tersebut dapat menjadi dasar karakter suatu marga pada bakteri (Tortora dkk., 2010).
Sel bakteri memiliki struktur dinding sel. Namun, struktur dinding sel pada bakteri berbeda dengan tumbuhan. Penyusun utama dinding sel pada bakteri adalah peptidoglikan, sedangkan penyusun utama dinding sel pada tumbuhan adalah selulosa (Tortora, 2010). Peptidoglikan adalah sebuah polisakarida yang terdiri dari dua macam gula turunan, yaitu N-acetylglucosamine (NAG) dan N-acetylmuramic acid (NAM). Selain itu, peptidoglikan juga disusun oleh beberapa asam amino, seperti D-alanine, L-alanine, D-glutamic acid, lysine atau struktur mirip analog asam amino yang disebut DAP. Semua komponen tersebut dikoneksikan sehingga membentuk struktur berulang yang disebut glycan tetrapeptide (Madigan dkk., 2011).
Baca juga: Struktur dan Fungsi Dinding Sel Bakteri
Selain dinding sel, sel bakteri mempunyai struktur lain yang juga khas, seperti kapsul, fimbriae, pili, flagela dan endospora. Kapsul merupakan lapisan polisakarida atau protein yang terletak di bagian terluar dari sel. Kapsul secara khas berikatan dengan kuat pada dinding sel atau berikatan secara kovalen pada peptidoglikan. Kapsul memiliki fungsi seperti media untuk melekatkan diri pada substrat padat dan mencegah sel dari kekeringan. Fimbriae dan pili adalah struktur filamen yang terbuat dari protein dan memanjang dari permukaan sel. Fimbriae berfungsi untuk melekatkan pada permukaan atau membentuk biofilm pada permukaan. Sementara itu, pili merupakan struktur mirip fimbriae, namun ukurannya lebih panjang dan jumlahnya lebih sedikit dibadingkan fimbriae. Pili berfungsi sebagai reseptor dari virus, memfasilitasi proses konjugasi, dan media untuk melekatkan sel pada jaringan inang (Madigan dkk., 2011).
Banyak bakteri dapat bergerak dengan “berenang”. Pergerakan tersebut dibantu oleh struktur yang disebut flagela. Cara kerjanya adalah dengan melakukan semacam rotasi atau putaran yang menyebabkan sel dapat ditarik dan didorong sehingga sel dapat berpindah tempat. Flagela bakteri tersusun atas protein yang disebut flagellin. Endospora adalah struktur khas yang biasanya muncul pada saat sel bakteri berada di kondisi yang tidak memungkinkan untuk melakukan pertumbuhan. Endospora terdehidrasi dan mengandung sejumlah agen proteksi seperti kompleks calcium-diphicolinic acid dan acid-soluble protein, yang tidak ada pada sel vegetatifnya. Endospora dapat tetap dorman sampai tak terbatas tetapi dapat bergerminasi dengan cepat ketika kondisi memungkinkan (Madigan dkk., 2011).
Bakteri telah dikelompokkan oleh para ahli berdasarkan tipe morfologi, fisiologi, dan genetikanya. Sejumlah taksa yang telah dikenal pada bakteri yaitu Proteobacteria, Actinobacteria, Spirochaetes, dan Cyanobacteria (Hogg, 2005). Selain pengelompokkan yang telah resmi diterima dalam taksonomi, terdapat juga jenis pengelompokkan tertentu yang didasarkan pada sifat yang khas dari sejumlah kelompok bakteri. Salah satu jenis pembagian bakteri tersebut adalah dengan membagi bakteri menjadi bakteri gram positif dan bakteri gram negatif (Hogg, 2005; Tortora dkk., 2010).
Perbedaan Bakteri Gram Positif dan Bakteri Gram Negatif
Bakteri gram positif dan bakteri gram negatif dibedakan berdasarkan struktur dinding selnya. Akibat struktur dinding sel yang berbeda, menimbulkan respon yang berbeda ketika dilakukan pewarnaan gram. Bakteri gram positif memiliki beberapa lapisan peptidoglikan sehingga lapisan peptidoglikannya tebal. Umumnya, 90% penyusun dinding sel bakteri gram positif merupakan peptidoglikan. Dinding sel bakteri gram positif mengandung teichoic acid. Ada dua tipe teichoic acid, yaitu lipoteichoic acid, yang menjangkau lapisan peptidoglikan dan terhubung ke membran plasma, dan wall teichoic acid, yang terhubung dengan lapisan peptidoglikan (Tortora dkk., 2010).
Berbeda halnya dengan bakteri gram negatif, yang memiliki lapisan peptidoglikan lebih tipis. Namun, dinding sel bakteri gram negatif mempunyai membran luar. Membran luar terdiri dari lipopolisakarida (LPS), lipoprotein, dan fosfolipid. Peptidoglikan terikat dengan lipoprotein di membran luar dan periplasma, yaitu struktur seperti gel yang berada di antara membran luar dan plasma membran. Selain itu, Dinding sel bakteri gram negatif tidak mengandung teichoic acid (Tortora dkk., 2010).
Perbedaan selanjutnya antara bakteri gram positif dan bakteri gram negatif adalah respon yang berbeda diantara keduanya ketika dilakukan pewarnaan gram. Bakteri gram positif akan tetap terwarnai kristal violet ketika dilakukan dekolorisasi dengan alkohol dan bakteri akan menampakkan warna biru atau ungu. Sebaliknya, bakteri gram negatif akan terdekolorisasi dengan alkohol dan terganti dengan pewarna lawan (counterstain) seperti safranin sehingga bakteri akan berwarna merah atau pink (Tortora dkk., 2010: 88).
Macam-Macam Pewarna Bakteri
Sel bakteri tidak berwarna sehingga sulit dan sukar diamati secara langsung. Untuk mempermudah pengamatan morfologi bakteri diperlukan pewarnaan. Proses pewarnaan bakteri lazim disebut pengecatan (Gandjar dkk., 1992). Zat yang digunakan untuk mewarnai bakteri termasuk biological dye. Zat pewarna/cat yang digunakan untuk mewarnai bakteri mempunyai dua sifat utama, yaitu mempunyai kelompok kromofor dan memiliki ikatan dengan sel secara ionik, kovalen, atau hidrofobik. Kromofor merupakan gugus pemberi warna dari biological dye (Prescott dkk., 2002).
Zat warna dapat dibedakan menjadi dua kelompok berdasarkan sifat muatannya, yaitu pewarna asam (acidic dyes) dan pewarna basa (basic dyes). Pewarna basa terdiri dari methylen blue, basic fuchsin, crystal violet, safranin yang memiliki muatan positif. Permukaan sel bakteri umumnya bermuatan negatif, sehingga pewarna basa sering digunakan dalam pengecatan struktur bakteri. Pewarna asam yakni eosin, rose bengal, acid fuchsin yang memiliki muatan negatif (Prescott dkk., 2002). Pewarna asam tidak dapat berikatan dengan kebanyakan bakteri karena muatan negatif pada zat warna akan ditolak dengan muatan negatif pada permukaan sel bakteri, sehingga pewarna asam mewarnai latar belakangnya (background) saja (Tortora dkk., 2010).
Ada tiga macam pengecatan yang umum digunakan, yaitu pengecatan negatif, pengecatan sederhana, dan pengecatan diferensial. Pengecatan negatif dilakukan untuk mewarnai latar belakang preparat dan bakteri tidak terwarnai. Pengecatan sederhana dilakukan dengan memakai satu macam larutan cat. Sel bakteri akan berwarna sesuai dengan jenis cat yang dipakai. Sementara itu, pengecatan diferensial dilakukan dengan memakai beberapa macam larutan zat. Hasil dari pengecatan diferensial mengelompokkan bakteri ke dalam kelompok-kelompok tertentu (Gandjar dkk., 1992).
Prinsip Pewarnaan Bakteri
Pengecatan negatif memiliki prinsip dasar, yaitu dengan mengkontraskan latar belakang sel (dibuat menjadi lebih gelap) sehingga sel yang tidak bewarna menjadi lebih terlihat. Pewarna yang digunakan adalah pewarna asam. Pengecatan negatif cocok digunakan untuk observasi bentuk sel, ukuran sel, dan kapsul (Tortora dkk., 2010).
Pengecatan sederhana menggunakan satu macam zat warna. Pengecatan sederhana biasanya digunakan untuk melihat bentuk dan susunan sel bakteri. Pewarna yang digunakan biasanya pewarna basa. Terkadang pada pengecatan sederhana digunakan zat mordant, yaitu zat yang dapat meningkatkan afinitas antara cat dengan sel bakteri sehingga sel bakteri lebih terwarnai (Tortora dkk., 2010).
Pengecatan diferensial menggunakan beberapa zat warna dan hasilnya dapat mengelompokkan bakteri ke dalam kelompok bakteri tertentu. Salah satu macam pengecatan diferensial adalah pengecatan gram. Pengecatan gram menggunakan empat macam larutan. Larutan pertama adalah cat utama, yaitu kristal violet. Larutan kedua adalah mordant, yaitu Gram’s iodine. Mordant berfungsi untuk meningkatkan afinitas antara cat dengan sel bakteri. Mordant akan berikatan kuat dengan kristal violet. Setelah diberi mordant, baik bakteri gram positif maupun negatif, akan tampak berwarna ungu atau biru. Larutan ketiga adalah zat pendekolorisasi, yaitu etanol atau aseton. Fungsi zat pendekolorisasi adalah untuk meluruhkan warna ungu pada bakteri gram negatif, sedangkan bakteri gram positif tetap berwarna ungu. Larutan keempat adalah zat pewarna lawan (counter stain), yaitu safranin. Fungsi zat pewarna lawan adalah akan memberikan warna pink pada bakteri gram negatif, sedangkan pada bakteri gram positif tetap berwarna ungu (Benson, 2001; Tortora dkk., 2010).
Pewarnaan Negatif
Pengecatan negatif menggunakan tinta cina atau nigrosin. Tinta cina atau nigrosin merupakan jenis pewarna asam dan bermuatan negatif. Tinta cina tidak akan bisa berikatan dengan dinding sel dari bakteri karena sama-sama bermuatan negatif, sehingga tinta cina hanya akan mewarnai permukaan preparat atau dengan kata lain membuat gelap latar belakang dari bakteri. Prinsip dari pengecatan negatif adalah membuat kontras latar belakang objek sehingga objek yang transparan dan tidak terwarnai menjadi lebih jelas terlihat (Benson, 2001; Harley & Prescott, 2002; Tortora dkk., 2010).
Pengecatan negatif tidak memerlukan proses fiksasi terlebih dahulu, karena proses fiksasi dapat membuat sel menjadi mengkerut. Biasanya, pengecatan negatif berfungsi untuk melihat bentuk, ukuran dan kapsul sel. Jika pada pengecatan negatif dilakukan juga proses fiksasi, akan membuat perubahan pada ukuran sel sehingga ukuran sel menjadi tidak akurat. Lagipula, salah satu fungsi dari proses fiksasi adalah untuk membuat proses pewarnaan bakteri menjadi lebih baik. Sementara itu, pengecatan negatif hanya mewarnai latar belakang dan tidak akan mewarnai permukaan sel sehingga proses fiksasi tidak perlu dilakukan (Benson, 2001).
Faktor-faktor yang memengaruhi proses pewarnaan adalah faktor warna, dinding sel bakteri, dan proses pewarnaan. Cat atau pewarna bisa bersifat asam atau basa, selanjutnya pemakaiannya disesuaikan dengan pengecatan yang akan dibuat. Jika akan melakukan pengecatan negatif, pewarna yang digunakan adalah pewarna asam karena pewarna asam tidak akan berikatan dengan dinding sel. Sementara itu, proses pewarnaan dapat memengaruhi baik tidaknya hasil pengecatan (Benson, 2001; Harley & Prescott, 2002).
Pewarnaan Sederhana
Contoh pewarnaan sederhana dengan menggunakan crystal violet. Permukaan sel bakteri akan menjadi berwarna ungu setelah diwarnai dengan pewarna crystal violet. Crystal violet adalah jenis pewarna basa yang bermuatan positif sehingga dapat berikatan dengan permukaan sel bakteri (Tortora dkk., 2010).
Sebelum melakukan proses pewarnaan sederana, perlu dilakukan proses fiksasi. Proses fiksasi mempunyai fungsi yang banyak dalam membantu proses pengecatan menjadi lebih baik. Salah satu fungsi dari fiksasi yaitu dapat menginaktivasi enzim yang dapat merusak morfologi sel atau menguatkan struktur sel sehingga dapat menyulitkan proses pewarnaan. Selain itu, fiksasi dapat mempertahankan posisi sel, membunuh sel, dan melekatkan sel dengan preparat sehingga sel bakteri tidak hilang ketika proses pencucian (Benson, 2001). Fiksasi dilakukan dengan cara melewatkan gelas objek di atas nyala api sebanyak 3-4 kali (Gandjar dkk., 1992).
Faktor-faktor yang memengaruhi pewarnaan sederhana adalah faktor cat, permukaan sel bakteri itu sendiri, dan faktor proses pewarnaan. Cat dan permukaan sel bakteri harus yang mempunyai ion yang berlawanan sehingga cat dapat berikatan dengan permukaan sel bakteri. Sebagai contoh, crystal violet yang memiliki ion bermuatan positif akan berikatan dengan permukaan sel bakteri yang umumnya memiliki ion bermuatan negatif. Proses pewarnaan sederhana yang cukup penting adalah pada saat proses fiksasi. Pengerjaan proses fiksasi yang tidak benar akan membuat pengecatan menjadi kurang baik, misalnya sel bakteri masih hidup, sel bakteri hilang ketika proses pencucian, dan sel tidak mampu diwarnai oleh zat pewarna (Benson, 2001; Prescott dkk., 2002; Tortora dkk., 2010).
Pewarnaan Gram
Pewarnaan gram menggunakan empat jenis larutan, yaitu larutan gram A, gram B, gram C, dan gram D. Setiap larutan tersebut mempunyai fungsi masing-masing yang dijelaskan sebagai berikut:
- Larutan gram A adalah cat utama, yaitu kristal violet.
- Larutan gram B adalah mordant, yaitu Gram’s iodine. Mordant berfungsi untuk meningkatkan afinitas antara cat dengan sel bakteri. Mordant akan berikatan kuat dengan kristal violet. Setelah diberi mordant, baik bakteri gram positif maupun negatif, akan tampak berwarna ungu atau biru.
- Larutan gram C adalah zat pendekolorisasi, yaitu etanol atau aseton. Fungsi zat pendekolorisasi adalah untuk meluruhkan warna ungu pada bakteri gram negatif, sedangkan bakteri gram positif tetap berwarna ungu.
- Larutan gram D adalah zat pewarna lawan (counter stain), yaitu safranin. Fungsi zat pewarna lawan adalah akan memberikan warna pink atau merah pada bakteri gram negatif, sedangkan pada bakteri gram positif tetap berwarna ungu (Benson, 2001; Tortora dkk., 2010).
Kompleks iodin-kristal violet akan terbentuk di dalam sel pada pewarnaan sel. Kompleks iodin-kristal violet akan terekstraksi oleh alkohol dari bakteri gram negatif, namun tidak pada bakteri gram positif. Hal tersebut disebabkan bakteri gram positif mempunyai lapisan peptidoglikan yang tebal. Peptidoglikan akan terdehidrasi oleh alkohol, menyebakan pori dinding tertutup dan mencegah kompleks iodin-kristal violet tidak keluar dari sel. Sebaliknya, pada bakteri gram negatif, alkohol berpenetrasi melewati LPS dan mengekstraksi kompleks iodin-kristal violet. Sebagai hasilnya, bakteri gram negatif akan terlihat tidak berwarna dan akan terwarnai oleh zat pewarna lawan (safranin), sedangkan bakteri gram positif akan tetap berwarna ungu (Madigan dkk., 2011).
Faktor-faktor yang memengaruhi proses pewarnaa gram adalah faktor cat, faktor dinding sel, dan proses pewarnaan. Cat yang digunakan tidak boleh yang sudah lama karena dapat memengaruhi hasil pengecatan. Struktur dinding sel juga memengaruhi hasil pengecatan, karena struktur dinding sel pada bakteri gram positif dan bakteri gram negatif berbeda. Proses pengecatan sel juga harus diperhatikan, misalnya pada tahap fiksasi dan pencucian. Umur biakan yang digunakan juga tidak boleh yang sudah tua, karena biakan yang sudah tua lebih mudah terdekolorisasi dibandingkan biakan yang masih muda sehingga bakteri gram positif bisa terlihat seperti bakteri gram negatif (Benson, 2001; Tortora dkk., 2010; Madigan dkk., 2011).
Referensi
- Black, J. G. 2008. Microbiology, 7th ed.
- Benson. 2001. Microbiological application lab manual, 8th ed.
- Harley & Prescott. 2002. Laboratory exercises in microbiology, 5th ed.
- Hogg, S. 2005. Essential microbiology.
- Bergey’s manual of systematic bacteriology: vol III The Firmicutes, 2nd ed.
- Madigan, M. T., J. M. Martinko, D. A. Stahl, D. P. Clark. 2011. Brock biology of microorganisms, 13th ed.
- Prescott, L. M., Harley, & Klein. 2002. Microbiology, 5th ed.
- Tortora, G. J., B. R. Funke & C. L. Case. 2010. Microbiology: An introduction, 10th ed.

Leave a Reply